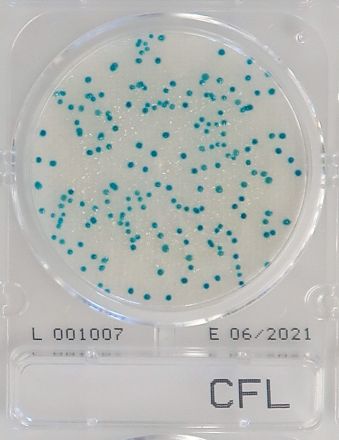
Compact Dry CF-L Coliform (for dairy products)

- Strona Główna
- Mikrobiologia
Mikrobiologia
Sprzęt i odczynniki do analiz mikrobiologicznych, w tym podłoża hodowlane, pożywki, odczynniki diagnostyczne oraz systemy do identyfikacji drobnoustrojów. Idealne do badań laboratoryjnych i kontroli jakości.
Mikrobiologia | Odczynniki, podłoża, testy, akcesoria
Zobacz jako Siatka Lista
Produkty 13-19 z 19
Strona
- Strona Poprzednie
- Strona 1
- Aktualnie czytasz stronę 2
-
-
-
-
Compact Dry CF Coliform
Chromogenne płytki do identyfikacji bakterii coli w żywności, wodzie i powierzchniach.
-
Compact Dry CF-L Coliform (for dairy products)
Specjalna pożywka CF do testów coli w produktach mlecznych.
-
Zobacz jako Siatka Lista
Produkty 13-19 z 19
Strona
- Strona Poprzednie
- Strona 1
- Aktualnie czytasz stronę 2
Filtruj produkty
Opcje zakupów
Cena
Producent